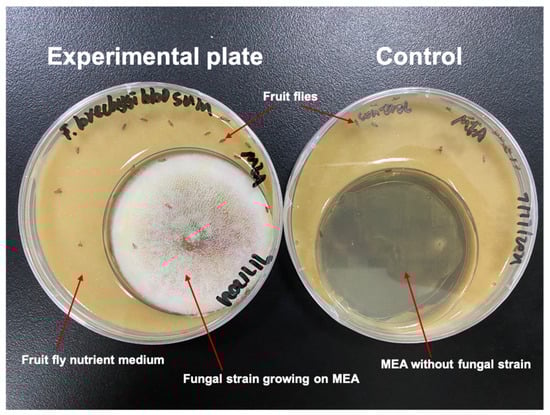

Abstract
Airborne fungi play an important role in air pollution and may have various negative effects on human health. In particular, Aspergillus fungi are pathogenic to humans and several domestic animals. In this work, Aspergillus strains isolated from airborne fungal communities sampled from different indoor and outdoor environments in Tianjin University were tested for pathogenicity on Drosophila melanogaster. Airborne fungi were sampled using an HAS-100B air sampler, over a one-year sampling period. Isolated fungal strains were identified based on morphological and molecular analysis. The Aspergillus-centered study was conducted as part of a larger work focusing on the total airborne fungal community in the analyzed environments, which yielded 173 fungal species. In this context, the genus Aspergillus showed the second-highest species richness, with 14 isolated species. Pathogenicity tests performed on male adults of Drosophila melanogaster through a bodily contact bioassay showed that all analyzed airborne Aspergillus species were pathogenic to fruit flies, with high insect mortality rates and shortened lifespan. All the studied fungi induced 100% mortality of fruit flies within 30 culture days, with one exception constituted by A. creber (39 days), while the shortest lifespan (17 days) was observed in fruit flies treated with A. tubingensis. Our results allow us to hypothesize that the studied airborne fungal species may have a pathogenic effect on humans, given the affinity between fruit flies and the human immune system, and may help to explain the health risk linked with Aspergillus fungi exposure in densely populated environments.
1. Introduction
Fungi are eukaryotic organisms defined by their heterotrophic means of acquiring nutrition from the environment [1]. They have been found to thrive in a large variety of environments, with many species being colonizers and parasites of plants and animals [2]. Since spores of various fungal species are dispersed in the atmosphere, airborne fungi play an important role in air pollution [3,4,5]. The diameter of airborne fungal spores normally ranges from 2 to 50 μm [6], which allows them to relatively easily penetrate the lower airways of the human respiratory tract, thus resulting in unavoidable inhalation, with consequent allergic sensitization caused by more than 80 genera of fungi [7]. The allergenic and pathogenic potential of a wide range of fungal taxa has been described. For example, the airborne fungal spores of Alternaria, Aspergillus, and Cladosporium have been found to be responsible for a number of respiratory diseases [8]. In particular, Aspergillus fungi are pathogenic to several animal species, including humans and domestic animals, and plants. For instance, A. flavus is a latent fungal pathogen that causes invasive aspergillosis, usually fatal infections in humans, by colonizing the lungs or respiratory tract. Patients infected with A. flavus often show reduced or compromised immune systems [9]. Aspergillus fumigatus can cause a range of pulmonary diseases, being one of the most common airborne fungal pathogens in humans, responsible for 90% of all invasive aspergillosis cases [10]. The clinical features of Aspergillus infections depend on the interplay between the fungi and the host, which is largely influenced by the host’s immune status [11]. Because people are frequently exposed to Aspergillus fungal spores in the majority of indoor and outdoor environments, it is of crucial importance to consider the associated health risk [12].
Recently, many studies have used fruit flies (Drosophila melanogaster) as model organisms to test the pathogenicity of fungal species [13]. Fruit flies are an attractive model for studying host–pathogen interactions, since their immune system shares traits with the mammalian innate immune system [14]. Indeed, fruit fly models have received widespread attention due to the high degree of gene conservation between these insects and humans, with 75% of human disease-related genes having corresponding genes in fruit flies [15,16,17]. The Drosophila melanogaster model has been recently used to analyze various human medical issues. For instance, a recent study performed by Wang et al. [18] showed that the Malpighian tubules in the renal system of fruit flies are similar to the mammalian renal tubules in both function and structure, pointing out that the kidney stone models of the fruit flies can supply quicker, cost-limited, and high-throughput screening platforms for the development of novel drugs to treat kidney stones [15]. Fruit flies have become an excellent model for cost-effectively and expediently studying nutrient-sensing pathways and metabolic homeostasis [18,19]. In a study conducted by Rani et al. [20], Malpighian tubules of Drosophila were used as a model to investigate the effects of chronic exposure to a high-sugar diet on renal tubules [21]. The embryotic, larval, and adult hearts of Drosophila are considered good models for studying human cardiovascular diseases, such as arrhythmia [22] and cardiomyopathy [11]. In addition, the life cycle of fruit flies, including the four developmental stages of embryo, larva, pupa, and adult, is very rapid compared with mammals, thus making these insects of great practical use for experiments. At room temperature, one pair of mating flies can produce hundreds of offspring within 12 days [15]. Lower breeding costs, a shorter experiment period, better-understood genome, and more abundant genetic modification techniques make the fruit fly a promising animal model for fundamental genetic studies, large-scale in vivo drug screening and high-throughput screening of putative fungal species virulence factors [20]. In a study conducted by [13], Drosophila melanogaster was used as a model host to assess the pathogenicity of Aspergillus flavus strains derived from clinical sources, showing that while all analyzed fungal strains were virulent, some of them were characterized by a significantly higher level of virulence, leading to a wide mortality rate in the tested insects [23]. The fungal species A. terreus, which is often reported as a cause of invasive aspergillosis, was observed to be able to infect the Toll-deficient (Tl−/−) D. melanogaster by [24].
At present, it is unclear whether different Aspergillus strains belonging to various species, such as A. oryzae and A. versicolor, vary in their virulence on humans and other animals. In this work, Aspergillus strains isolated from airborne fungal communities sampled from different indoor and outdoor environments in Tianjin University, Tianjin, China, were tested for pathogenicity on Drosophila melanogaster in order to understand the human health risk associated with the exposure to Aspergillus fungi present in the air of a densely populated public environment.
2. Materials and Methods
2.1. Sampling and Fungal Identification
Sampling of airborne fungi was carried out in Tianjin University campus, Tianjin city, China. This study was conducted as part of a larger work, which analyzed the whole airborne fungal community in the selected university environments [25]. Six different sites, including one outdoor and five indoor environments, were selected to collect the air samples (see Yuan et al., 2022 [25] for details). The sampling was conducted every month, from June 2020 to May 2021. Air samples were collected using an air sampler (HAS-100B) (Hengao T&D, Beijing, China), which was operated at a flow rate of 100 L/min and rotating dish speed of 0–4 rpm for 10 min at each study site. A Petri dish (9.0 cm diameter) containing Malt Extract Agar (MEA), added with ampicillin to prevent bacterial growth, was used for each air sampling. In order to understand the human traffic influence on the airborne fungal community, two different sampling times were chosen, including (i) the off-peak period, when there were no or there were very few human activities, and (ii) the peak period, when there were maximum levels of human presence and activities. After sampling, the plates were put into an incubator at 25 °C in the darkness for 5–7 days and examined every day for fungal growth. For isolation, observed fungal colonies in each plate were picked up and inoculated in new plates (6.0 cm diameter).
All the isolated Aspergillus strains identified using molecular and morphological analyses were selected for subsequent pathogenicity tests. Fungal morphology was characterized based on macroscopic and microscopic observations. Microscopy was carried out using a Nikon ECLIPSE Ci-L microscope (Tokyo, Japan) to examine fungal morphological characteristics, including hyphae, conidiophores, conidia, etc. [26,27,28]. For molecular identification, DNA extraction of Aspergillus strains was conducted based on the cetyltrimethylammonium bromide method [29,30]. Fungal ITS regions were amplified via polymerase chain reaction (PCR), using the primers ITS1 and ITS4 [31]. Amplifications were performed following the conditions described in Yuan et al. [25]. The resulting PCR products were electrophoresed in 1% agarose gel and purified with the QIAEX II Gel Extraction Kit (QIAGEN) following the manufacturer’s instructions. DNA sequencing was performed at Tsingke Biological Technology Company (Beijing, China). Sequences were edited, assembled using the program Sequencher 4.1 for MacOS X, and analyzed with BLAST searches against the National Center for Biotechnology Information (NCBI) sequence database (http://www.ncbi.nlm.nih.gov/Blast.cgi, accessed on 25 March 2023). Fungal DNA sequences amplified from the isolated Aspergillus stains were submitted to GenBank under accessions OM237038, OM236862, OM237112, OM237034, OM236745, OM236800, OM236675, OM237191, OM236713, OM236847, OM237054, OM237070, OM236676, and OM236712.
Phylogenetic analysis was conducted with Mega v. 7.0 [32], DNA sequences were aligned with Clustal X v. 2.1 [33], and both a neighbour-joining tree and a maximum likelihood tree against selected database sequences were constructed using Kimura 2-parameter distances, with bootstrapping of 1000 replicates [34]. Metarhizium anisopliae was used as outgroup to root the Aspergillus fungi trees.
All analyzed fungal strains were deposited in the LP Culture Collection (personal culture collection held in the laboratory of Prof. Lorenzo Pecoraro), at the School of Pharmaceutical Science and Technology, Tianjin University, Tianjin, China.
2.2. Drosophila Maintenance
Pathogenicity tests were performed on male adults of Drosophila melanogaster to minimize sex-dependent effects on susceptibility to infection. Wild-type (WT) Dijon 2000 (Di2) flies were used because they are less laborious to manipulate compared to other types [35]. Fly reproduction was carried out in an insectary under controlled temperature conditions (25 °C). Drosophila melanogaster individuals were kept in transparent bottles (150 mL) containing 30 mL of nutrient medium constituted by yeast 24.5 g, corn 50 g, agar 10 g, sucrose 7.25 g, brown sugar 30 g, 4 mL propionic acid, and 10% antibiotic (5.1 g Methyl 4-hydroxybenzoate dissolved in 50 mL absolute alcohol × 3) in 1 L of distilled water. The bottles of fruit flies with the nutrient medium were maintained at 25 °C temperature under a 12 h dark/12 h light cycle.
2.3. Pathogenicity Test
A bodily contact bioassay tested the pathogenicity of the airborne Aspergillus isolates toward fruit flies. Aspergillus isolates were grown on Malt Extract Agar (MEA) in small Petri dishes (6.0 cm diameter), which were placed inside larger Petri dishes (9.0 cm diameter) filled with the fruit fly nutrient medium (Figure 1). In such experimental conditions, the fruit flies were in constant contact, during the whole period of observation, with a source of fungal particles represented by the same surface of actively growing and sporulating mycelium for each fungal strain, which was cultivated under exactly the same environmental parameters, for the same number of days, in order to make the experiments homogeneous and reliable. To identify the male D. melanogaster from the individuals contained in the transparent bottles, we used a stereoscopic microscope equipped with a controllable CO2-flow fly pad. A sterilized brush was used to separate the flies under the microscope, and 20 anaesthetized male flies were placed into each Petri dish prepared with the nutrient medium and the selected Aspergillus strain. We prepared 5 plate replicates to test each fungal strain and 1 control plate (without fungi). The experimental plates were kept at room temperature 25 °C and monitored every 24 h to detect fly mortality. The daily number of dead flies was recorded until all individuals were dead. Fungal growth was observed daily on dead flies, until fungal sporulation was visible, using a Nikon ECLIPSE Ci-L microscope (Tokyo, Japan) to verify that the tested fungi were responsible for the observed Drosophila individuals’ mortality.
Figure 1.
Example of pathogenicity test. In the experimental plate (left), the fruit flies were exposed to the fungus and could feed on the nutrient medium. In the control plate (right), the smaller capsule only contained MEA, without fungal inoculum.
3. Results
3.1. Diversity of Aspergillus Strains Isolated from the Analyzed Air Environments
This study focused on Aspergillus fungi as members of the total airborne fungal community constituted by 173 species in 74 genera and 56 families, out of 641 fungal strains isolated during a larger work performed by our research group in the six investigated locations at Tianjin University campus [25]. In the context of the whole analyzed airborne fungal community, the genus Aspergillus showed the second-highest species richness, with 14 species isolated from different locations, months, and levels of human activity (Table 1). Within the genus Aspergillus, A. flavus was the most abundant species, with seven strains isolated from the studied air environments.

Table 1.
Aspergillus species detected in indoor and outdoor environments of Tianjin University, from DNA extracted from isolated strains.
Phylogenetic analysis clarified the relationship of airborne fungi isolated from indoor and outdoor environments in Tianjin University within the genus Aspergillus. Sequences retrieved from the university campus-analyzed strains could be aligned with GenBank sequences from various Aspergillus species collected in different environments and countries, including indoor and outdoor air in China, Slovakia, Turkey, Czech Republic, and Korea, oil-contaminated soils, and plant tissues. Both in the neighbor-joining tree and in the maximum likelihood tree from the Aspergillus dataset (Figure 2 and Figure 3), the sequence OM236675 from a strain isolated in the library of Tianjin University fell in a cluster, including A. flavus and A. oryzae. The sequence OM236862 obtained from a strain collected in a Chinese student’s dorm during the off-peak period was phylogenetically close to A. flavus previously found in outdoor air in China. The fungal sequence OM236712 obtained from canteen 3 at the peak period was segregated in a cluster with GenBank sequences from A. westerdijkiae. The three sequences OM236800 from canteen 5 at the peak period, OM236847 from a foreign student’s dorm at the peak period, and OM237112 from the library formed clades with their best BLAST matches, A. ochraceus MT582750, Aspergillus sp. MN634437, and A. japonicus MF073328, respectively. The fungal sequences OM236745, amplified from a foreign student’s dorm off-peak period, and OM237070 from Peiyang Square, co-segregated into a cluster included their best BLAST matches A. niger MT620753 and A. tubingensis MT443912 (Figure 2 and Figure 3, Table 1). The sequence OM237191 from the airborne fungal strain isolated from canteen 3 during the peak period clustered with its best BLAST match A. proliferans (KX696376) and A. pseudoglaucus previously found in outdoor air in China. The sequence OM237038 retrieved from canteen 3 during the peak period fell in a cluster with its best BLAST matches, Fungal sp. KX098100 and A. creber KT310996, as well as with other GenBank Aspergillus sequences. The sequence OM237034 from a strain isolated in Peiyang Square clustered with A. nidulans, while the sequence OM236676 collected from the library showed phylogenetic relationships with several GenBank Aspergillus sequences, including its best BLAST match A. versicolor. The sequence isolated from the canteen 3 peak period (OM236713) clustered with A. protuberus and A. creber sequences previously collected from indoor air in China and Turkey, respectively. The sequence OM237054 retrieved from a Chinese student’s dorm at the peak period was closely related to A. sydowii.

Figure 2.
Neighbour-joining phylogenetic tree showing the relationship between the Aspergillus sequences obtained from Tianjin University campus airborne fungal communities (*) and selected database relatives. Kimura 2-parameter distances were used. Bootstrap values were based on percentages of 1000 replicates. Metarhizium anisopliae (AF218207) was used as the outgroup. 3CP = Canteen 3 Peak, 3CO = Canteen 3 Off-peak, 5CP = Canteen 5 Peak, 5CO = Canteen 5 Off-peak, CDP = Chinese students Dorm Peak, CDO = Chinese students Dorm Off-peak, FDP = Foreign students Dorm Peak, FDO = Foreign students Dorm Off-peak, LIB = Library, PS = Peiyang Square.

Figure 3.
Maximum likelihood phylogenetic tree showing the relationship between the Aspergillus sequences obtained from Tianjin University campus airborne fungal communities (*) and selected database relatives. Kimura 2-parameter distances were used. Bootstrap values were based on percentages of 1000 replicates. Metarhizium anisopliae (AF218207) was used as the outgroup. 3CP = Canteen 3 Peak, 3CO = Canteen 3 Off-peak, 5CP = Canteen 5 Peak, 5CO = Canteen 5 Off-peak, CDP = Chinese students Dorm Peak, CDO = Chinese students Dorm Off-peak, FDP = Foreign students Dorm Peak, FDO = Foreign students Dorm Off-peak, LIB = Library, PS = Peiyang Square.
3.2. Pathogenicity of Aspergillus Fungi on Fruit Flies
The analyzed Aspergillus species displayed a different effect on the Drosophila fly lifespan (Figure 4). All the studied fungi induced 100% mortality of fruit flies within 30 culture days, with one exception constituted by A. creber. Drosophila individuals treated with the latter Aspergillus species showed the longest lifespan (39 days), while the shortest lifespan (17 days) was observed in fruit flies treated with A. tubingensis. The fruit fly’s lifespan in the control group was 50 days, which was considerably longer than in all 14 tested Aspergillus species, thus demonstrating the efficacy of the bodily contact bioassay technique of inoculation.

Figure 4.
Lifespan (days) and mortality rate (%) of fruit flies (Drosophila melanogaster) treated with Aspergillus species.
Some fungal species showed an identical effect on the fruit fly lifespan. For instance, A. protuberus and A. ochraceus shortened the insect lifespan to 25 days, while A. japonicus and A. sydowii produced 100% mortality in the model organism after 30 days (Figure 5). Aspergillus versicolor, Aspergillus sp., A. westerdijkiae, and A. oryzae showed a similar shortening effect on Drosophila lifespan (18, 19, 20, and 21 days, respectively). Aspergillus proliferans, A. flavus, and A. nidulans produced a similar effect by reducing the fruit fly lifespan to 27, 28, and 29 days, respectively.

Figure 5.
Lifespan of fruit flies (Drosophila melanogaster) treated with Aspergillus fungi.
The mortality ratio of fruit flies was observed and recorded every day. We summarized the results with 5-day intervals in Table 2. The analyzed Aspergillus species induced different death ratios on fruit flies. In most cases, the mortality rate was within 5% after five culture days, except for A. tubingensis, A. creber, and A. niger that produced 11%, 9%, and 6% mortality rates, respectively (Table 2). The earliest death of fruit flies was recorded with A. creber after 3 days. No mortality was recorded during the first five culture days for the fruit flies treated with A. versicolor, A. oryzae, and A. proliferans. After culture day 10, for most of the Aspergillus species, the Drosophila mortality rate was less than 20%, except for A. tubingensis, A. protuberus, A. versicolor, A. westerdijkiae, and A. oryzae, which showed significantly higher mortality rates (62%, 45%, 34%, 32%, and 25%, respectively). The mortality rate of flies for A. tubingensis, A. versicolor, and A. westerdijkiae was higher than 80% after 15 days. Aspergillus sp. showed a remarkable increase in the fly death rate, from 24% to 100%, in just 4 days, after culture day 15 (Figure 6). The four fungal species A. tubingensis, A. versicolor, Aspergillus sp., and A. westerdijkiae induced 100% mortality of flies in 20 culture days, while the control group only showed 8% mortality in the same period. For A. protuberus and A. ochraceus strains, 100% mortality of flies was reached in 25 culture days, whereas the mortality after the same number of culture days was slightly lower with A. tubingensis (95%) and considerably lower with A. proliferans, A. japonicus, and A. flavus (82–85%). After 30 culture days, no Drosophila individuals survived with the tested Aspergillus species, with the sole exception represented by A. creber, which only induced 59% mortality in the treated insects in a month. After 35 culture days, the fruit fly death rate was 80% in the presence of A. creber and 38% in the control group.

Table 2.
Effect of Aspergillus fungal species on fruit fly (Drosophila melanogaster) mortality.

Figure 6.
Mortality (%) of fruit flies (Drosophila melanogaster) treated with Aspergillus fungi, in five-days intervals.
In most cases, dead flies inoculated with Aspergillus species showed fungal growth on their bodies, while no external presence of fungi was observed on the flies exposed to Aspergillus sp. and A. sydowii after death. More specifically, fruit flies treated with A. tubingensis, A. versicolor, A. westerdijkiae, A. oryzae, A. niger, and A. flavus displayed clearly visible fungal colonies 3–4 days after death (Figure 7), while A. protuberus, A. ochraceus, A. proliferans, A. nidulans, A. japonicus, and A. creber hyphal growth was recorded on dead flies after 7–8 days.

Figure 7.
Aspergillus flavus sporulating on dead wild-type Drosophila melanogaster individuals.
4. Discussion
This study shed light on the pathogenicity of airborne Aspergillus fungal strains isolated from indoor and outdoor environments in Tianjin University campus, a densely populated major university area located in the third-largest municipality of North China [36]. The use of Drosophila melanogaster as a model organism in the performed fungal pathogenicity experiments allowed us to hypothesize the risk for human health associated with the presence of the analyzed fungi in the air, given the remarkable affinities in immune systems and disease-related genes between fruit flies and humans [14,17]. All tested Aspergillus fungi consistently reduced the lifespan of fruit flies when compared to the control group, with significant variability in pathogenicity observed among the different analyzed fungal species.
The genus Aspergillus includes about 339 species, more than 40 of them being known as opportunistic pathogens to plants, animals, and humans [37,38]. In our study, fruit flies treated with A. tubingensis showed the shortest lifespan and highest mortality rate. Strong pathogenicity was previously observed by Zahran et al. (2017) [39] using an A. tubingensis isolate collected from dead bed bugs, which showed rapid mortality of the tested Cimex hemipterus insects from day 6 to day 12, ranging from 13% to 90%, depending on the different doses of the inoculated fungus. In addition, Aspergillus tubingensis was described as an opportunistic pathogen in an immunocompromised patient with maxillary osteomyelitis [40]. Aspergillus versicolor exhibited a shortening effect on fruit fly lifespan similar to that of A. tubingensis. In a previous study, mice exposed to A. versicolor aerosol inhalation for 15–20 min showed upper respiratory tract irritation [41]. This fungal species is also known as a plant pathogen, causing fruit rot disease in tomatoes and sour rot disease in grapes [42,43], while it was reported as a post-harvest pathogen on jute seeds [44]. Among the tested Aspergillus species, A. westerdikijae was found to be the fourth most virulent to fruit flies. A study conducted by Baggio et al. (2015) [45] reported that A. westerdijkiae was pathogenic to adult females and oothecae of the American cockroach (Periplaneta americana, Blattidae). This fungus is also known to produce ochratoxin A (OTA) as a contaminant in coffee beans in many parts of the world, including Vietnam [46] and Thailand [47]. The mycotoxin OTA, produced by the secondary metabolism of numerous filamentous fungal species, can have various harmful consequences in mammals [48]. Another of our tested Aspergillus species, A. oryzae, which showed pathogenicity on D. melanogaster, was previously recorded for the first time as an entomopathogenic fungus on locusts (Locusta migratoria) by Zhang et al. [49]. Aspergillus niger and A. flavus, two common fungal pathogens on plants and animals [50], confirmed their pathogenicity in our work by drastically shortening the lifespan of Drosophila melanogaster fruit flies. Our results are in agreement with previous findings by Ramírez-Camejo et al. [51], who showed pathogenic effects of A. niger and A. flavus in humans, using the same model organism. All five above-mentioned Aspergillus species (A. tubingensis, A. versicolor, A. westerdijkiae, A. niger, and A. flavus) were previously found during screening for potentially pathogenic isolates from problematic buildings with moisture damage or complaints about indoor air quality in Helsinki, Finland [52]. Aspergillus protuberus and A. ochraceus showed a similar shortening effect on the lifespan of fruit flies in this study [53] discovered that A. protuberus caused a rare case of kerion-type scalp mycosis in humans, whereas a study conducted by Castillo et al. (2000) [54] revealed that A. ochraceus significantly decreased fecundity in the Ceratitis capitata fruit fly. The analyzed fungal species A. proliferans, A. nidulans, and A. japonicus induced similar high mortality in male flies in this study. Aspergillus proliferans and A. nidulans are both known to cause diseases in immunocompromised patients, including onychomycosis, caused by A. proliferans [55], and chronic granulomatous disease (CGD), caused by A. nidulans [56]. Ford and Friedman [57] showed that A. japonicus was pathogenic to mice in a study comparing the relative virulence of several species of Aspergillus.
Except for Aspergillus sp. and A. sydowii, all the pathogenic airborne Aspergillus species analyzed in our study showed fungal growth on the dead insects, including conidiophores and conidia, which is a common feature observed in previous studies using Drosophila flies to test fungal species pathogenicity [58,59]. In spite of the absence of visible fungal structures on the dead bodies of flies treated with Aspergillus sp. and A. sydowii, the high mortality ratio and limited lifespan of inoculated flies provided the evidence of the pathogenicity of these two fungal species. A study by Bobadilla-Carrillo et al. [60] reported on the presence of A. sydowii as a potential pathogenic fungus in marine and freshwater fish commercial feeds.
Aspergillus creber inoculation resulted in the lowest mortality and least pronounced lifespan-shortening effects on fruit flies in our whole study, although this fungus caused the earliest fruit fly death records among all the analyzed airborne Aspergillus species, on culture day 3. In a previous study, A. creber was found to produce sterigmatocystin in a stored rice sample [61]. Sterigmatocystin, a polyketide mycotoxin that is also known to contaminate various foods, such as spices, grains, bread, beer, and cheeses, may be responsible for serious health problems in humans and other animals [62]. Aspergillus creber was described as a contaminant in a commercial freshwater fish feed [60]. Our control group showed a standard fly mortality rate and lifespan (50 days), with no fungal growth after death, as reported in numerous previous studies [63,64,65], thus confirming the validity of our experimental procedure.
In conclusion, we discovered a wide range of pathogenicity in different Aspergillus species isolated from the air of Tianjin University indoor and outdoor environments. All airborne Aspergillus species tested in this study were pathogenic to fruit flies, with high mortality rates and shortened lifespan. Our results allow us to hypothesize that the studied airborne fungal species may have a pathogenic effect on humans, given the affinity between fruit flies and the human immune system, and may help to explain the health risk linked with Aspergillus fungi exposure in densely populated environments. The presence and concentration of potential pathogenic fungi, such as Aspergillus species, in the air of public areas characterized by high human activity should be monitored in order to determine any possible hazardous effect on human health and to prevent diseases associated with microbial pollution.
Author Contributions
L.P. conceived the study; samples were collected by M.M.H.N. and Z.M.Q.; the experiments were designed and supervised by L.P.; laboratory experiments and analysis were performed by M.M.H.N., Z.M.Q., A.A.Q.A.A.-S. and M.H.M.M.; results were analyzed by M.M.H.N., Z.M.Q. and L.P.; M.M.H.N. prepared the original draft under the guidance and critical review of L.P. All authors have read and agreed to the published version of the manuscript.
Funding
This research received no external funding.
Institutional Review Board Statement
Not applicable.
Informed Consent Statement
Not applicable.
Data Availability Statement
Data presented in this study can be found as part of the manuscript. The fungal DNA sequences amplified during this study are available at GenBank under accessions OM237038, OM236862, OM237112, OM237034, OM236745, OM236800, OM236675, OM237191, OM236713, OM236847, OM237054, OM237070, OM236676, and OM236712.
Conflicts of Interest
The authors declare no conflict of interest.
References
- Anees-Hill, S.; Douglas, P.; Pashley, C.H.; Hansell, A.; Marczylo, E.L. A Systematic Review of Outdoor Airborne Fungal Spore Seasonality across Europe and the Implications for Health. Sci. Total Environ. 2022, 818, 151716. [Google Scholar] [CrossRef] [PubMed]
- Sun, J.-Z.; Liu, X.-Z.; McKenzie, E.H.C.; Jeewon, R.; Liu, J.-K.; Zhang, X.-L.; Zhao, Q.; Hyde, K.D. Fungicolous Fungi: Terminology, Diversity, Distribution, Evolution, and Species Checklist. Fungal Divers. 2019, 95, 337–430. [Google Scholar] [CrossRef]
- Nageen, Y.; Asemoloye, M.D.; Põlme, S.; Wang, X.; Xu, S.; Ramteke, P.W.; Pecoraro, L. Analysis of culturable airborne fungi in outdoor environments in Tianjin, China. BMC Microbiol. 2021, 21, 134. [Google Scholar] [CrossRef] [PubMed]
- Nageen, Y.; Wang, X.; Pecoraro, L. Seasonal variation of airborne fungal diversity and community structure in urban outdoor environments in Tianjin, China. Front Microbiol. 2023, 13, 1043224. [Google Scholar] [CrossRef]
- Shelton, B.G.; Kirkland, K.H.; Flanders, W.D.; Morris, G.K. Profiles of Airborne Fungi in Buildings and Outdoor Environments in the United States. Appl. Environ. Microbiol. 2002, 68, 1743–1753. [Google Scholar] [CrossRef]
- Patel, T.Y.; Buttner, M.; Rivas, D.; Cross, C.; Bazylinski, D.A.; Seggev, J. Variation in airborne fungal spore concentrations among five monitoring locations in a desert urban environment. Environ. Monit. Assess. 2018, 190, 634. [Google Scholar] [CrossRef] [PubMed]
- Horner, W.E.; Helbling, A.; Salvaggio, J.E.; Lehrer, S.B. Fungal Allergens. Clin. Microbiol. Rev. 1995, 8, 161–179. [Google Scholar] [CrossRef]
- O’Gorman, C.M.; Fuller, H.T. Prevalence of Culturable Airborne Spores of Selected Allergenic and Pathogenic Fungi in Outdoor Air. Atmos. Environ. 2008, 42, 4355–4368. [Google Scholar] [CrossRef]
- Kurup, V.P.; Shen, H.; Banerjee, B. Respiratory Fungal Allergy. Microbes Infect. 2000, 2, 1101–1110. [Google Scholar] [CrossRef]
- Dagenais, T.R.T.; Keller, N.P. Pathogenesis of Aspergillus fumigatus in Invasive Aspergillosis. Clin. Microbiol. Rev. 2009, 22, 447–465. [Google Scholar] [CrossRef]
- Taghli-lamallem, O.; Akasaka, T.; Hogg, G.; Nudel, U.; Yaffe, D.; Chamberlain, S.; Ocorr, K.; Bodmer, R. Dystrophin deficiency in Drosophila reduces lifespan and causes a dilated cardiomyopathy phenotype. Aging Cell 2008, 7, 237–249. [Google Scholar] [CrossRef] [PubMed]
- Mousavi, B.; Hedayati, M.T.; Hedayati, N.; Ilkit, M.; Syedmousavi, S. Aspergillus Species in Indoor Environments and Their Possible Occupational and Public Health Hazards. Curr. Med. Mycol. 2016, 2, 36–42. [Google Scholar] [CrossRef]
- Ramírez-Camejo, L.A.; Torres-Ocampo, A.P.; Agosto-Rivera, J.L.; Bayman, P. An Opportunistic Human Pathogen on the Fly: Strains of Aspergillus flavus Vary in Virulence in Drosophila melanogaster. Med. Mycol. 2014, 52, 211–219. [Google Scholar] [CrossRef] [PubMed]
- Krappmann, S. Tools to Study Molecular Mechanisms of Aspergillus Pathogenicity. Trends Microbiol. 2006, 14, 356–364. [Google Scholar] [CrossRef]
- Bier, E. Drosophila, the golden bug, emerges as a tool for human genetics. Nat. Rev. Genet. 2005, 6, 9–23. [Google Scholar] [CrossRef]
- Denning, D.W. Invasive Aspergillosis. Clin. Infect. Dis. 1998, 26, 781–803. [Google Scholar] [CrossRef] [PubMed]
- Miller, J.; Chi, T.; Kapahi, P.; Kahn, A.J.; Kim, M.S.; Hirata, T.; Romero, M.F.; Dow, J.A.T.; Stoller, M.L. Drosophila melanogaster as an Emerging Translational Model of Human Nephrolithiasis. J. Urol. 2013, 190, 1648–1656. [Google Scholar] [CrossRef]
- Wang, S.; Ju, Y.; Gao, L.; Miao, Y.; Qiao, H.; Wang, Y. The Fruit Fly Kidney Stone Models and Their Application in Drug Development. Heliyon 2022, 8, e09232. [Google Scholar] [CrossRef] [PubMed]
- Bharucha, K.N. The Epicurean Fly: Using Drosophila melanogaster to Study Metabolism. Pediatr. Res. 2009, 65, 132–137. [Google Scholar] [CrossRef]
- Rani, L.; Saini, S.; Shukla, N.; Kar, D.; Kumar, N. High Sucrose Diet Induces Morphological, Structural and Functional Impairments in the Renal Tubules of Drosophila melanogaster: A Model for Studying Type-2 Diabetes Mediated Renal Tubular Dysfunction. Insect Biochem. Mol. Biol. 2020, 125, 103441. [Google Scholar] [CrossRef]
- Hofker, M.; Wijmenga, C. A supersized list of obesity genes. Nat. Genet. 2009, 41, 139–140. [Google Scholar] [CrossRef]
- Smith, W.W.; Thomas, J.; Liu, J.; Li, T.; Moran, T.H. From Fat Fruit Fly to Human Obesity. Physiol. Behav. 2014, 136, 15–21. [Google Scholar] [CrossRef]
- Chang, K.; Kim, A.C.; Jurado, J.E.; Donaghy, H.J. Aspergillus Pleural Empyema in a Chronic Smoker−A Case Report and Review of Literature. J. Med. Mycol. 2022, 32, 101299. [Google Scholar] [CrossRef] [PubMed]
- Ben-Ami, R.; Lamaris, G.A.; Lewis, R.E.; Kontoyiannis, D.P. Interstrain Variability in the Virulence of Aspergillus fumigatus and Aspergillus terreus in a Toll-Deficient Drosophila Fly Model of Invasive Aspergillosis. Med. Mycol. 2010, 48, 310–317. [Google Scholar] [CrossRef] [PubMed][Green Version]
- Yuan, C.; Wang, X.; Pecoraro, L. Environmental Factors Shaping the Diversity and Spatial-Temporal Distribution of Indoor and Outdoor Culturable Airborne Fungal Communities in Tianjin University Campus, Tianjin, China. Front. Microbiol. 2022, 13, 928921. [Google Scholar] [CrossRef] [PubMed]
- Lu, Y.; Wang, X.; Almeida, L.C.S.d.S.; Pecoraro, L. Environmental Factors Affecting Diversity, Structure, and Temporal Variation of Airborne Fungal Communities in a Research and Teaching Building of Tianjin University, China. J. Fungi 2022, 8, 431. [Google Scholar] [CrossRef]
- Pecoraro, L.; Rasmussen, H.N.; Gomes, S.I.F.; Wang, X.; Merckx, V.S.F.T.; Cai, L.; Rasmussen, F.N. Fungal diversity driven by bark features affects phorophyte preference in epiphytic orchids from southern China. Sci. Rep. 2021, 11, 11287. [Google Scholar] [CrossRef]
- Wang, X.; Pecoraro, L. Diversity and Co-Occurrence Patterns of Fungal and Bacterial Communities from Alkaline Sediments and Water of Julong High-Altitude Hot Springs at Tianchi Volcano, Northeast China. Biology 2021, 10, 894. [Google Scholar] [CrossRef]
- Doyle, J.J.; Doyle, J.L. A Rapid DNA Isolation Procedure for Small Quantities of Fresh Leaf Tissue. Phytochem. Bull. 1987, 19, 11–15. [Google Scholar]
- Pecoraro, L.; Girlanda, M.; Kull, T.; Perini, C.; Perotto, S. Molecular identification of root fungal associates in Orchis pauciflora Tenore. Plant Biosyst. 2012, 146, 985–991. [Google Scholar] [CrossRef]
- White, T.J.; Bruns, T.; Lee, S.; Taylor, J. Amplification and Direct Sequencing of Fungal Ribosomal RNA Genes for Phylogenetics. PCR Protoc. A Guid. Methods Appl. 1990, 18, 315–322. [Google Scholar]
- Kumar, S.; Stecher, G.; Tamura, K. MEGA7: Molecular Evolutionary Genetics Analysis Version 7.0 for Bigger Datasets. Mol. Biol. Evol. 2016, 33, 1870–1874. [Google Scholar] [CrossRef]
- Larkin, M.A.; Blackshields, G.; Brown, N.P.; Chenna, R.; McGettigan, P.A.; McWilliam, H.; Valentin, F.; Wallace, I.M.; Wilm, A.; Lopez, R. Clustal W and Clustal X Version 2.0. Bioinformatics 2007, 23, 2947–2948. [Google Scholar] [CrossRef] [PubMed]
- Felsenstein, J. Confidence Limits on Phylogenies: An Approach Using the Bootstrap. Evolution 1985, 39, 783–791. [Google Scholar] [CrossRef] [PubMed]
- Wang, Y.; Misto, M.; Yang, J.; Gehring, N.; Yu, X.; Moussian, B. Toxicity of Dithiothreitol (DTT) to Drosophila melanogaster. Toxicol. Rep. 2021, 8, 124–130. [Google Scholar] [CrossRef]
- Boxer, B. Tianjin, China, Encyclopedia britannica. Available online: https://www.britannica.com/place/Tianjin-China (accessed on 8 May 2023).
- Samson, R.A.; Visagie, C.M.; Houbraken, J.; Hong, S.-B.; Hubka, V.; Klaassen, C.H.W.; Perrone, G.; Seifert, K.A.; Susca, A.; Tanney, J.B.; et al. Phylogeny, identification and nomenclature of the genus Aspergillus. Stud. Mycol. 2014, 78, 141–173. [Google Scholar] [CrossRef]
- Varga, J.; Samson, R.A. Aspergillus in the Genomic Era; Wageningen Academic Publishers: Wageningen, The Netherlands, 2008; pp. 1–334. [Google Scholar]
- Zahran, Z.; Nor, N.M.I.M.; Dieng, H.; Satho, T.; Ab Majid, A.H. Laboratory Efficacy of Mycoparasitic Fungi (Aspergillus tubingensis and Trichoderma harzianum) against Tropical Bed Bugs (Cimex hemipterus)(Hemiptera: Cimicidae). Asian Pac. J. Trop. Biomed. 2017, 7, 288–293. [Google Scholar] [CrossRef]
- Bathoorn, E.; Escobar Salazar, N.; Sepehrkhouy, S.; Meijer, M.; de Cock, H.; Haas, P.-J. Involvement of the Opportunistic Pathogen Aspergillus tubingensis in Osteomyelitis of the Maxillary Bone: A Case Report. BMC Infect. Dis. 2013, 13, 59. [Google Scholar] [CrossRef]
- Korpi, A.; Kasanen, J.P.; Raunio, P.; Pasanen, A.L. Acute Effects of Aspergillus versicolor Aerosols on Murine Airways. Indoor Air 2003, 13, 260–266. [Google Scholar]
- Chandra Mohana, N.; Narendra Kumar, H.K.; Mahadevakumar, S.; Sowmya, R.; Sridhar, K.R.; Satish, S. First Report of Aspergillus versicolor Associated with Fruit Rot Disease of Tomato (Solanum lycopersicum) from India. Plant Dis. 2022, 106, 1300. [Google Scholar] [CrossRef]
- Nally, M.C.; Pesce, V.M.; Maturano, Y.P.; Toro, M.E.; Combina, M.; Castellanos de Figueroa, L.I.; Vazquez, F. Biocontrol of Fungi Isolated from Sour Rot Infected Table Grapes by Saccharomyces and Other Yeast Species. Postharvest Biol. Technol. 2013, 86, 456–462. [Google Scholar] [CrossRef]
- Aidoo, K.E. Post-Harvest Storage and Preservation of Tropical Crops. Int. Biodeterior. Biodegrad. 1993, 32, 161–173. [Google Scholar] [CrossRef]
- Baggio, M.V.; Ferreira, M.d.C.; Monteiro, A.C.; Maldonado Junior, W.; Lemos, M.V.F. Pathogenicity of Aspergillus westerdijkiae to Females and Oothecae of Periplaneta americana. Ciência Rural. 2015, 46, 20–25. [Google Scholar] [CrossRef]
- Leong, S.L.; Hien, L.T.; An, T.V.; Trang, N.T.; Hocking, A.D.; Scott, E.S. Ochratoxin A-producing Aspergilli in Vietnamese Green Coffee Beans. Lett. Appl. Microbiol. 2007, 45, 301–306. [Google Scholar] [CrossRef]
- Noonim, P.; Mahakarnchanakul, W.; Nielsen, K.F.; Frisvad, J.C.; Samson, R.A. Isolation, Identification and Toxigenic Potential of Ochratoxin A-Producing Aspergillus Species from Coffee Beans Grown in Two Regions of Thailand. Int. J. Food Microbiol. 2008, 128, 197–202. [Google Scholar] [CrossRef]
- Nielsen, K.F.; Mogensen, J.M.; Johansen, M.; Larsen, T.O.; Frisvad, J.C. Review of Secondary Metabolites and Mycotoxins from the Aspergillus niger Group. Anal. Bioanal. Chem. 2009, 395, 1225–1242. [Google Scholar] [CrossRef] [PubMed]
- Zhang, P.; You, Y.; Song, Y.; Wang, Y.; Zhang, L. First Record of Aspergillus oryzae (Eurotiales: Trichocomaceae) as an Entomopathogenic Fungus of the Locust, Locusta Migratoria (Orthoptera: Acrididae). Biocontrol. Sci. Technol. 2015, 25, 1285–1298. [Google Scholar] [CrossRef]
- Paulussen, C.; Hallsworth, J.E.; Álvarez-Pérez, S.; Nierman, W.C.; Hamill, P.G.; Blain, D.; Rediers, H.; Lievens, B. Ecology of Aspergillosis: Insights into the Pathogenic Potency of Aspergillus fumigatus and Some Other Aspergillus Species. Microb. Biotechnol. 2017, 10, 296–322. [Google Scholar] [CrossRef]
- Ramírez-Camejo, L.A.; Maldonado-Morales, G.; Bayman, P. Differential Microbial Diversity in Drosophila melanogaster: Are Fruit Flies Potential Vectors of Opportunistic Pathogens? Int. J. Microbiol. 2017, 2017, 8526385. [Google Scholar] [CrossRef]
- Andersson, M.; Varga, A.; Mikkola, R.; Vornanen-Winqvist, C.; Salo, J.; Kredics, L.; Kocsubé, S.; Salonen, H. Aspergillus was the Dominant Genus Found during Diversity Tracking of Potentially Pathogenic Indoor Fungal Isolates. Pathogens 2022, 11, 1171. [Google Scholar] [CrossRef]
- Jia, J.; Chen, M.; Mo, X.; Liu, J.; Yan, F.; Li, Z.; Xie, S.; Chen, D. The First Case Report of Kerion-Type Scalp Mycosis Caused by Aspergillus protuberus. BMC Infect. Dis. 2019, 19, 506. [Google Scholar] [CrossRef]
- Castillo, M.-A.; Moya, P.; Hernández, E.; Primo-Yúfera, E. Susceptibility of Ceratitis capitata Wiedemann (Diptera: Tephritidae) to Entomopathogenic Fungi and Their Extracts. Biol. Control 2000, 19, 274–282. [Google Scholar] [CrossRef]
- López, A.L.; Bestina, G.; Amador, T.; Javier, L.; Tovar, M.; Stephanie, B.; Ramírez, H.; Hernández, F.H. Aspergillus proliferans Onychomycosis Forming Fungal Masses. Dermatol. Cosmética Médica Y Quirúrgica 2021, 19, 174–179. [Google Scholar]
- Bastos, R.W.; Valero, C.; Silva, L.P.; Schoen, T.; Drott, M.; Brauer, V.; Silva-Rocha, R.; Lind, A.; Steenwyk, J.L.; Rokas, A.; et al. Functional Characterization of Clinical Isolates of the Opportunistic Fungal Pathogen Aspergillus nidulans. mSphere 2020, 5, e00153-20. [Google Scholar] [CrossRef]
- Ford, S.; Friedman, L. Experimental Study of the Pathogenicity of Aspergilli for Mice. J. Bacteriol. 1967, 94, 928–933. [Google Scholar] [CrossRef]
- Jiji, T.; Praveena, R.; Babu, K.; Naseema, A.; Anitha, N. Three promising fungal strains pathogenic to fruit flies. In Proceedings of the 7th International Symposium on Fruit Flies of Economic Importance, Salvador, Brazil, 10–15 September 2006; pp. 175–177. [Google Scholar]
- Rohlfs, M. Density-Dependent Insect-Mold Interactions: Effects on Fungal Growth and Spore Production. Mycologia 2005, 97, 996–1001. [Google Scholar] [CrossRef] [PubMed]
- Bobadilla-Carrillo, G.I.; Magallón-Servín, P.; López-Vela, M.; Palomino-Hermosillo, Y.A.; Ramírez-Ramírez, J.C.; Gutiérrez-Leyva, R.; Ibarra-Castro, L.; Bautista-Rosales, P.U. Characterization and Proliferation Capacity of Potentially Pathogenic Fungi in Marine and Freshwater Fish Commercial Feeds. Arch. Microbiol. 2020, 202, 2379–2390. [Google Scholar] [CrossRef]
- Kobayashi, N.; Sakurai, K.; Nakarai, R.; Shigaki, K.; Horikawa, K.; Honda, M.; Sugiura, Y.; Watanabe, M.; Takino, M.; Sugita-Konishi, Y. Microflora of Mycotoxigenic Fungi in Rice Grains in Kyushu Region of Japan and Their Changes during Storage under Non-Controlled Conditions. Biocontrol. Sci. 2019, 24, 161–166. [Google Scholar] [CrossRef]
- Díaz Nieto, C.H.; Granero, A.M.; Zon, M.A.; Fernández, H. Sterigmatocystin: A Mycotoxin to Be Seriously Considered. Food Chem. Toxicol. 2018, 118, 460–470. [Google Scholar] [CrossRef]
- Piper, M.D.W.; Partridge, L. Drosophila as a Model for Ageing. Biochim. Biophys. Acta-Mol. Basis Dis. 2018, 1864 Pt A, 2707–2717. [Google Scholar] [CrossRef]
- Staats, S.; Wagner, A.E.; Kowalewski, B.; Rieck, F.T.; Soukup, S.T.; Kulling, S.E.; Rimbach, G. Dietary Resveratrol Does Not Affect Life Span, Body Composition, Stress Response, and Longevity-Related Gene Expression in Drosophila melanogaster. Int. J. Mol. Sci. 2018, 19, 223. [Google Scholar] [CrossRef] [PubMed]
- Sun, Y.; Yolitz, J.; Wang, C.; Spangler, E.; Zhan, M.; Zou, S. Aging Studies in Drosophila melanogaster. Methods Mol. Biol. 2013, 1048, 77–93. [Google Scholar] [PubMed]
Disclaimer/Publisher’s Note: The statements, opinions and data contained in all publications are solely those of the individual author(s) and contributor(s) and not of MDPI and/or the editor(s). MDPI and/or the editor(s) disclaim responsibility for any injury to people or property resulting from any ideas, methods, instructions or products referred to in the content. |
© 2023 by the authors. Licensee MDPI, Basel, Switzerland. This article is an open access article distributed under the terms and conditions of the Creative Commons Attribution (CC BY) license (https://creativecommons.org/licenses/by/4.0/).